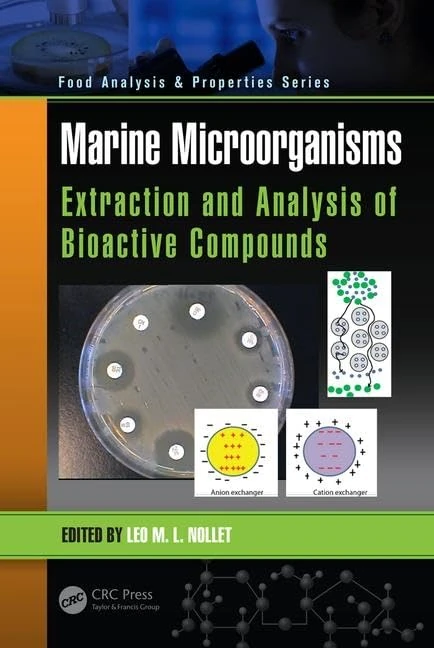
Marine Microorganisms: Extraction and Analysis of Bioactive Compounds (Food Analysis & Properties)

We can't find the internet
Attempting to reconnect
Something went wrong!
Hang in there while we get back on track

£162.06
CRC Press Marine Products for Healthcare: Functional and Bioactive Nutraceutical Compounds from the Ocean: 13 (Functional Foods and Nutraceuticals)
Price data last checked 135 day(s) ago - refreshing...
We'll watch every seller, every day. One email when your price arrives.
It has never been this cheap. We have no record of a lower price.
£162 today · cheaper than every other day in the last 24 months
NEW HERE?
Amazon shows you one price. We show you all of them.
Tosheroon watches Amazon prices so you don't have to. Every product on Amazon has a price history — we make it visible. Set the price you'd actually pay, and we'll email you the second it gets there. No app, no account, one email.
WHAT'S ON THIS PAGE
when this has been cheap or pricey
where the price is heading next
all-time high & low, recent range
name your number, we'll email you
Price History & Forecast
Grey patches = out of stock. Cheaper = lower on the chart. Hover for exact prices.
Last 596 days • 596 data points (No recent data available)
Price Distribution
Price distribution over 596 days • 1 price levels
Price Analysis
Most common price: £162 (596 days, 100.0%)
Price range: £162 - £162
Price levels: 1 different prices over 596 days
Description
Product Specifications
- Brand
- CRC Press
- Format
- Hardcover
- ASIN
- 1420052632
- Domain
- Amazon UK
- Release Date
- 20 October 2008
- Listed Since
- 30 December 2006
Barcode
No barcode data available
Similar Products You Might Like

CRC Press Marine-Based Bioactive Compounds in Nutraceuticals
CRC Press

CRC Press - Marine Polysaccharides: Food Applications Book
CRC Press

Coral Reef Marine Plants of Hainan Island
Academic Press

Progress in the Chemistry of Organic Natural Products 111
Springer

Progress in the Chemistry of Organic Natural Products 111
Springer

Sustainable Global Resources of Seaweeds Volume 2: Food, Pharmaceutical and Health Applications
Springer

Advances in Natural Products Discovery (Chemistry Research and Applications)
Marine Microorganisms: Extraction and Analysis of Bioactive Compounds (Food Analysis & Properties)
CRC Press

Interrelationships Between Corals and Fisheries: 16 (CRC Marine Biology)
CRC Press

Marine Pharmacognosy: Trends and Applications
CRC Press
Seaweed Bioactives: Extraction and Characterization Techniques (Functional Foods and Nutraceuticals)
CRC Press

Innovative and Emerging Technologies in the Bio-marine Food Sector: Applications, Regulations, and Prospects
Academic Press

Handbook of Anticancer Drugs from Marine Origin
Springer

Marine Faunal Diversity in India: Taxonomy, Ecology and Conservation
Academic Press

Bioactive Compounds from Plant Origin: Extraction, Applications, and Potential Health Benefits (Innovations in Plant Science for Better Health)
CRC Press

Mediterranean Cold-Water Corals: Past, Present and Future: Understanding the Deep-Sea Realms of Coral: 9 (Coral Reefs of the World, 9)
Springer

Harnessing Marine Macroalgae for Industrial Purposes in an Australian Context: Emerging Research and Opportunities (Advances in Environmental Engineering and Green Technologies)
IGI Global

Recent Advances in Micro- and Macroalgal Processing: Food and Health Perspectives (IFST Advances in Food Science)
Wiley-Blackwell

Springer Corals and Reefs: From the Beginning to an Uncertain Future
Springer

Seaweed in Health and Disease Prevention
Academic Press

Sustainable Global Resources Of Seaweeds Volume 1: Bioresources , cultivation, trade and multifarious applications
Springer

Mesophotic Coral Ecosystems: 12 (Coral Reefs of the World, 12)
Springer

Marine Organisms as Model Systems in Biology and Medicine: 65 (Results and Problems in Cell Differentiation, 65)
Springer

Nutritional Marine Life
CRC Press